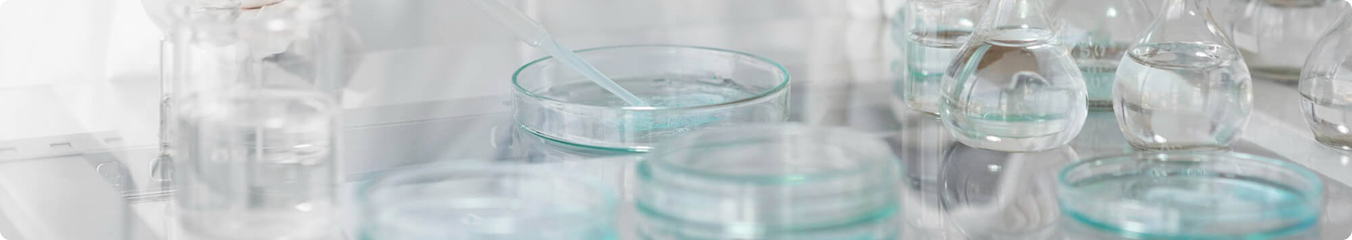

Продукция PRIME применяется в системах водоподготовки и очистки сточных вод в горнорудной, углеобогатительной, пищевой, целлюлозно-бумажной, нефтегазовой, химической и других отраслях промышленности, а также в системах водоподготовки и очистки сточных вод.
Использование реагентов и комплексных решений PRIME позволяет повысить эффективность технологических процессов, стабилизировать работу оборудования, снизить расход реагентов и обеспечить соблюдение отраслевых, экологических и технологических требований.
В линейку PRIME входят неорганические и органические коагулянты, полиакриламидные флокулянты анионного, катионного и неионогенного типа, а также бинарные системы «коагулянт + флокулянт», применяемые в процессах флотации, сгущения и обезвоживания.
Для каждой задачи подбираются индивидуальные технологические решения с учётом свойств и состава обрабатываемой среды, технологической схемы, параметров оборудования и требований к конечному результату.

Флокулянты PRIME применяются в технологических процессах, связанных с укрупнением частиц, ускорением осаждения и повышением эффективности механического разделения фаз. Они используются как в системах очистки воды, так и при сгущении пульп, обезвоживании шламов, переработке минерального сырья и работе с промышленными суспензиями.
В основе продуктов лежит полиакриламид, модифицированный под различные типы заряда и условия эксплуатации. Линейка включает анионные флокулянты серии PRIME A, катионные PRIME C и неионогенные PRIME N, что позволяет подбирать решения под широкий спектр промышленных задач.
Анионные флокулянты PRIME A применяются для работы с минеральными пульпами, шламами и суспензиями, содержащими положительно заряженные частицы.
Продукты характеризуются молекулярной массой от 5 до 200 млн, вязкостью раствора 7–20 при концентрации 1,0 г/л, степенью гидролиза 1–33%, содержанием твёрдого вещества не менее 88% и поставляются в виде белого порошка. Используются в процессах флотации, сгущения, осветления и обезвоживания, включая очистку шахтных вод.
Основные отрасли применения — пищевая, углеобогатительная, горнорудная и золотоизвлекательная промышленность.
Катионные флокулянты PRIME C предназначены для процессов обезвоживания осадков и шламов, где требуется высокая степень влагоотдачи и формирование прочного осадка.
Серия характеризуется молекулярной массой 8–15 млн, вязкостью раствора 30–300 при концентрации 1,0 г/л, катионностью 20–60%, содержанием твёрдого вещества не менее 88%, pH 6,0–8,0 и порошкообразной формой. Применяется в пищевой, целлюлозно-бумажной, нефтегазовой, химической промышленности, а также в муниципальных и промышленных схемах обработки осадков.
Неионогенные флокулянты PRIME N применяются в процессах, где требуется стабильная работа в широком диапазоне pH и при сложном минеральном составе среды. Продукты PRIME N221B и PRIME N222B используются при сгущении концентратов и хвостов руд, а также в золотоизвлекательной промышленности.
Коагулянты PRIME применяются в технологических процессах, где требуется дестабилизация дисперсных систем и укрупнение мелкодисперсных и коллоидных частиц. Такие процессы характерны как для систем подготовки и очистки воды, так и для обработки пульп, суспензий, шламов и технологических растворов в различных отраслях промышленности.
Основу линейки составляют неорганические соли алюминия и железа, которые нейтрализуют электрический заряд частиц и обеспечивают их агрегацию в устойчивые, укрупненные флокулы, пригодные для последующего осаждения, флотации или механического отделения. Дополнительно компания развивает линейку органических коагулянтов, расширяя возможности применения реагентов PRIME в сложных технологических процессах.

Ассортимент коагулянтов PRIME включает полиоксихлорид алюминия, железосодержащие коагулянты, а также органические продукты на основе полиаминов и полидадмаков. Органические коагулянты используются как самостоятельные реагенты либо в сочетании с минеральными коагулянтами для повышения эффективности процессов и снижения объёма образующегося осадка.
Флагманскими продуктами линейки являются PRIME-AC–30, PRIME-AC–28, PRIME-AC–31 и Prime F|||S, продемонстрировавшие устойчивые результаты при эксплуатации на промышленных и муниципальных объектах различных отраслей.
Полиоксихлорид алюминия PRIME применяется в процессах обработки природных и оборотных вод, технологических сред, пульп, суспензий и сточных вод. Коагулянт эффективно работает при низких температурах и высокой мутности, обеспечивает стабильное формирование хлопьев и устойчивость технологических режимов.
В линейку полиоксихлорида алюминия входят продукты PRIME-AC-30, PRIME-AC-28 и PRIME-AC-31, отличающиеся степенью основности, физико-химическими характеристиками и целевыми областями применения. Продукты используются в процессах коагуляции, флотации, осветления, а также в бинарных системах совместно с флокулянтами PRIME.
PRIME-AC–30 — полиоксихлорид алюминия в виде твёрдого порошка белого или светло-жёлтого цвета. Содержит оксид алюминия (Al₂O₃) не менее 29%, нерастворимые вещества — менее 0,3%, основность — 45–55%, pH 1% водного раствора — 3,5–5,0.
Продукт является универсальным коагулянтом и применяется в широком спектре задач — от муниципальных схем очистки воды до промышленных процессов флотации, осветления и обезвоживания осадков и шламов. PRIME-AC–30 стабильно работает с оборотными и технологическими средами различного состава и используется на предприятиях различных отраслей промышленности.
PRIME-AC–28 — полиоксихлорид алюминия в виде твёрдого порошка жёлтого цвета, без запаха. Содержит Al₂O₃ 29±1%, нерастворимые вещества — не более 1,5%, основность — 70–90%, pH 1% раствора — 3,5–5,0.
Коагулянт ориентирован на пищевую промышленность, сельское хозяйство и технологические процессы с высокой концентрацией взвешенных веществ. Применяется в схемах коагуляции, флотации и бинарной обработки, в том числе при работе с технологическими и производственными сточными водами.
PRIME-AC–31 — полиоксихлорид алюминия в виде твёрдого порошка жёлтого цвета. Содержит Al₂O₃ не менее 29%, нерастворимые в воде вещества — не более 0,1%, основность — 40–90%, pH 1% водного раствора — 3,5–5,0. Продукт характеризуется пониженным содержанием примесей тяжёлых металлов, включая ртуть, мышьяк, свинец, кадмий и шестивалентный хром.
PRIME-AC–31 является высокоэффективным коагулянтом и применяется в процессах осветления и очистки вод, обработки промышленных и оборотных сред, а также в системах подготовки технологических растворов и суспензий. Обеспечивает стабильную работу в широком диапазоне условий и используется на предприятиях различных отраслей промышленности.

Железосодержащие коагулянты PRIME применяются в процессах, где важны биостойкость, устойчивость к органическим загрязнениям и эффективное устранение запахов. Они используются при обработке технологических сред, сточных и оборотных вод, а также осадков и шламов в различных отраслях промышленности.
В линейку входят Prime F|||S, а также гранулированные продукты Prime F|||SG2 и Prime F|||SG, отличающиеся гранулометрическим составом. Продукты применяются в процессах коагуляции, флотации, осветления и в бинарных системах совместно с флокулянтами PRIME.
Prime F|||S — коагулянт на основе сульфата трёхвалентного железа в виде твёрдого порошка от светло-жёлтого до ярко-рыжего цвета. Содержит Fe3+ не менее 19%, основность — 45–55%, pH 1% раствора — 2,0–3,0.
Продукт предназначен для биостойкой обработки и устранения запахов, особенно в средах с высоким содержанием органических веществ. Используется в процессах очистки сточных и оборотных вод, флотации, осветления и обезвоживания осадков в пищевой, целлюлозно-бумажной, нефтяной и химической промышленности.
Prime F|||SG2 — гранулированный сульфат трёхвалентного железа, удобный для хранения, транспортировки и дозирования. По области применения и ключевым характеристикам продукт сопоставим с Prime F|||S и используется в типовых технологических схемах, где требуется железосодержащий коагулянт.
Prime F|||SG — коагулянт на основе сульфата трёхвалентного железа в виде гранул жёлтого цвета. Содержит Fe3+ не менее 20%, Fe2+ — не более 1%, свободную серную кислоту — не более 1,5%, основность — 8–16%, pH 1% водного раствора — 2,0–3,0. Нерастворимые в воде вещества — не более 1%. Продукт характеризуется низким содержанием примесей тяжёлых металлов, включая мышьяк, ртуть, никель и свинец. Насыпная плотность — около 1,2 г/см3.
Prime F|||SG применяется для эффективной обработки сред с повышенным содержанием органических веществ, включая процессы биостойкой обработки и устранения запахов, а также в системах очистки сточных и оборотных вод, флотации, осветления и разделения суспензий..
Органические коагулянты на основе полиаминов и полидадмаков используются как самостоятельные реагенты или в сочетании с минеральными коагулянтами. Это жидкие продукты, эффективно работающие в широком диапазоне pH и щёлочности.
По сравнению с неорганическими коагулянтами они не изменяют pH обработанной среды, не увеличивают содержание растворённых металлов и обеспечивают минимальное образование осадка. Линейка органических коагулянтов PRIME активно развивается и дополняет решения на основе алюминия и железа.

Для подбора оптимального реагента под конкретные условия эксплуатации предусмотрена онлайн-форма запроса. Пользователь может указать отрасль, характеристики среды, существующую технологическую схему и требования к результату.
На основе полученных данных разрабатывается программа лабораторных испытаний, по результатам которых формируются рекомендации для проведения опытно-промышленных испытаний. При необходимости выполняется индивидуальная разработка технологических решений.


Комплексные решения PRIME основаны на бинарных системах «коагулянт + флокулянт», позволяющих максимально эффективно использовать потенциал обоих типов реагентов. Такая схема обработки снижает расход реагентов, уменьшает содержание общего железа и алюминия, а также сокращает концентрацию взвешенных веществ.
Бинарные системы адаптируются под процессы:
флотации
сгущения
обезвоживания
Решения PRIME применяются в пищевой, углеобогатительной, горнорудной, золотоизвлекательной, целлюлозно-бумажной промышленности, а также на муниципальных и промышленных объектах, где ключевыми требованиями являются стабильность процессов и экономическая эффективность.
